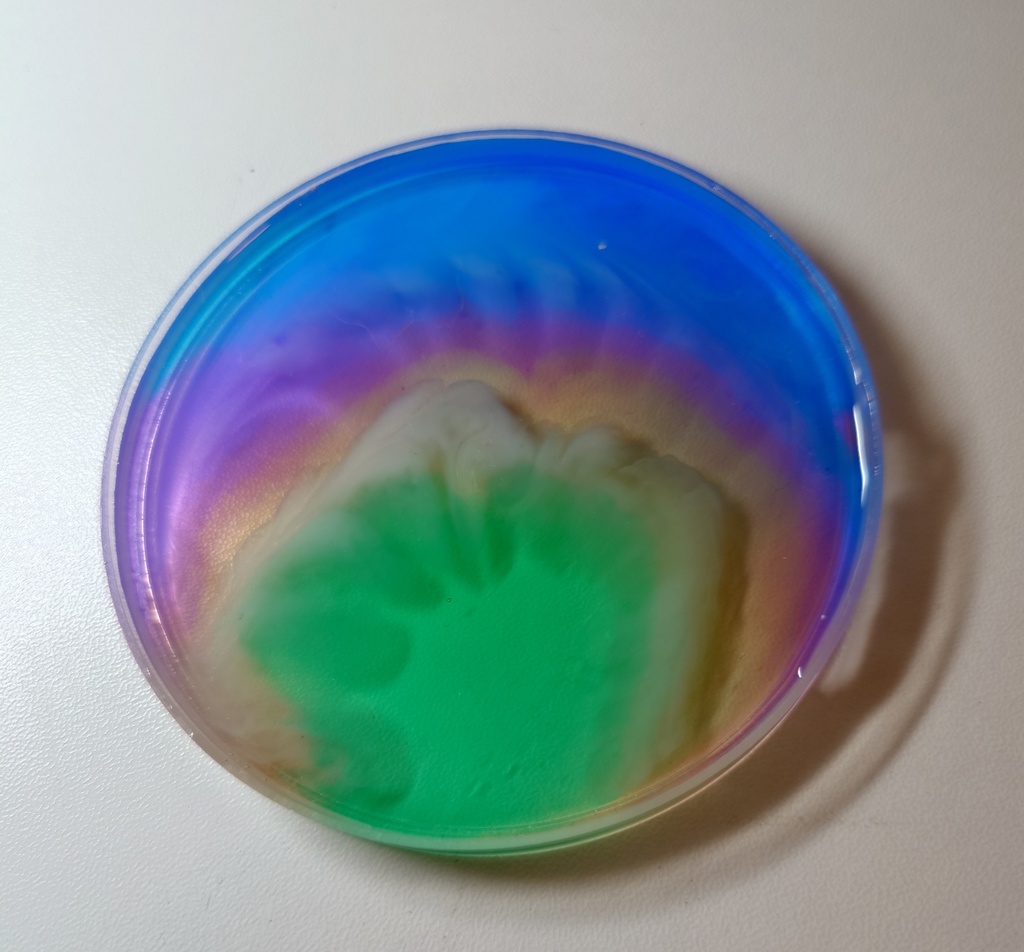
マーブル台(レジン)
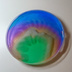

マーブル台(レジン)
Physical (worldwide shipping)
- Ships within 14 days1 left in stockShips by Anshin-BOOTH-PackPhysical (direct)700 JPY
Physical (ship to Japan)
- Ships within 14 days1 left in stockShips by Anshin-BOOTH-PackPhysical (direct)700 JPY
See More